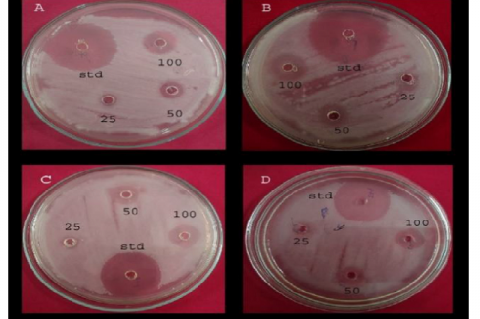
The antibacterial activity of methanolic leaf extract of Holigarna ferruginea against A- Klebsiella pneumonia MTCC
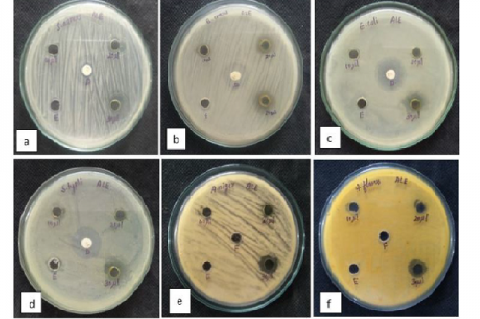
Antimicrobial analysis of ethanol leaf extracts of Tinospora crispa against (a) Staphylococus aureus
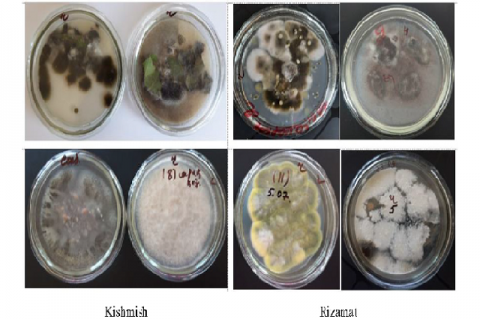
Microbiome of diseased «Kishmish» and «Rizamat» grape varieties grown in culture media

Asian Journal of Biological and Life sciences, Vol 11, Issue 3, Sep-Dec, 2022
Recent Articles
Review Article
Preparedness in Combating the New COVID-19 Variant, Omicron in Saudi Arabia: A Review of Existing Strategies, Findings, and Implications for the Future
Suhaj Abdulsalim,Mohammed Salim Karattuthodi,Shabeer Ali Thorakkattil,Sainul Abideen Parakkal,Ajmal Karumbaru Kuzhiyil,Hafees Madathil,Gladson Skaria,Syed Iqbal Mohiuddin,Mohammed Abdul Kare Amer,Mazhuvanchery Kesavan Unnikrishnan
Asian J. Biol. Life Sci.,11(3):624-630 DOI: 10.5530/ajbls.2022.11.83 Published: Thu, 19-Jan-2023 Read More
Review Article
A Systematic Review on the Antibacterial Activity of Punica granatum L. against E. coli
Jeen Hernandez Magbuhat,Paulene Dinglasan Bool,Kristine Jane Rios Olit,Diana Rose Olavi Sales,Axel An Lee Mangalonzo,Franzyn Evol Uy Montances,Sophia Galang Gallardo,Gilmar Chrys Parr Salenga,Carl Vincent De Arizala
Asian J. Biol. Life Sci.,11(3):631-639 DOI: 10.5530/ajbls.2022.11.84 Published: Thu, 19-Jan-2023 Read More
Review Article
A Systematic Review of Phenolic and Flavonoid Compounds of Oryza sativa (Balatinaw Rice) Extracts against Cancer
Talosig KA,Vargas MB,Tolentino RC,Biscocho EG,De Pano VB,Diolanda AB,Garcia CL,Parale AC,Bercede DH
Asian J. Biol. Life Sci.,11(3):640-646 DOI: 10.5530/ajbls.2022.11.85 Published: Thu, 19-Jan-2023 Read More
Review Article
A Review on Botanical Characteristics, Bioactive Compounds and Traditional Uses of Some Selected Unconventional Fruits of Upper Brahmaputra Valley, Assam
Bristy Borgohain,Aandrisha Borthakur,Bijoy Neog,Pranit Saikia
Asian J. Biol. Life Sci.,11(3):647-655 DOI: 10.5530/ajbls.2022.11.86 Published: Thu, 19-Jan-2023 Read More
Review Article
Automated Detection of Plant Diseases- A Promising Tool for Smart Agriculture
Panchashree Das,Dipen Nama Adhikary,Priyabrata Sen
Asian J. Biol. Life Sci.,11(3):656-661 DOI: 10.5530/ajbls.2022.11.87 Published: Thu, 19-Jan-2023 Read More
Research Article
A Comparative Study of Avian Diversity at Three Selected Sites of Porbandar, Gujarat, India
Malay A. Vyas,Jatin V. Raval
Asian J. Biol. Life Sci.,11(3):662-677 DOI: 10.5530/ajbls.2022.11.88 Published: Thu, 19-Jan-2023 Read More
Original Article
Physico-chemical and Microbiological Characterisation of Pheasant and Salted Fish (Lanhouin) Produced and Sold in Lomé
Reine Bayi Dossou,Magnou-Léléng Atakora,Mamatchi Mélila,Kouassi Soncy,Mensah Kangni-Dossou,Damintoti Simpliste Karou,Yaovi Améyapoh,Messanvi Gbéassor
Asian J. Biol. Life Sci.,11(3):678-683 DOI: 10.5530/ajbls.2022.11.89 Published: Thu, 19-Jan-2023 Read More
Research Article
In-vitro Assessment of Antibacterial and Electrochemical Properties of Methanolic Leaf Extracts of Holigarna ferruginea March. The Poisonous Plant Species in the Western Ghats
Kumbar Mudakappa Manjunath,Yelugere Linganaik Krishnamurthy
Asian J. Biol. Life Sci.,11(3):684-689 DOI: 10.5530/ajbls.2022.11.90 Published: Sat, 21-Jan-2023 Read More
Research Article
Different Types of Gene Expression Profiles and Pathway Enrichment Analysis of Oral Dysplastic Keratinocyte Cells Caused by Heavy Smoking
Sudeshna Sengupta,Malavika Bhattacharya
Asian J. Biol. Life Sci.,11(3):690-697 DOI: 10.5530/ajbls.2022.11.91 Published: Thu, 19-Jan-2023 Read More
Research Article
Production of Two Novel Polyketide Pigments by Fusarium chlamydosporum
Tessy Anu Thomas,Abhilashini M,Deepesh Kumar,Dhruva Kumar,Karthik S,Sharmila Tirumale
Asian J. Biol. Life Sci.,11(3):698-703 DOI: 10.5530/ajbls.2022.11.92 Published: Thu, 19-Jan-2023 Read More
Research Article
Antioxidant Potential, Anthelmintic Activity and Quantification of Total Phenols, Tannins, Flavonoids of E. milii Leaf and Flower Extracts
Ch Pradyutha,Uma Maheswara Rao
Asian J. Biol. Life Sci.,11(3):704-711 DOI: 10.5530/ajbls.2022.11.93 Published: Thu, 19-Jan-2023 Read More
Research Article
Phytochemical Screening, Antioxidant and Antimicrobial Activity of the Ethanolic leaf Extract of Tinospora crispa (L.) Miers [Menispermaceae]
Akila Shree,C Krishnaveni
Asian J. Biol. Life Sci.,11(3):712-718 DOI: 10.5530/ajbls.2022.11.94 Published: Thu, 19-Jan-2023 Read More
Research Article
A Study of Length Weight Relationship and Feeding Habit in Two Threatened Fish Species Glossogobius giuris and Nandus nandus from Sessa River, Dibrugarh, Assam, North-East India
Simi Gogoi,Shatabdi Deb,Shyama Prasad Biswas
Asian J. Biol. Life Sci.,11(3):719-723 DOI: 10.5530/ajbls.2022.11.95 Published: Thu, 19-Jan-2023 Read More
Original Article
In vitro Antioxidant and Antibacterial Activities of Jatropha heynei Leaf Extract and GC-MS Profiling
Gowdru Basanna Ashoka,Manchanahally Byrappa Shivanna
Asian J. Biol. Life Sci.,11(3):724-730 DOI: 10.5530/ajbls.2022.11.96 Published: Thu, 19-Jan-2023 Read More
Research Article
Synthesis and Characterization of CuO Nanoparticles and Acute Lethal Studies in Eudrilus eugeniae Earthworm
Mohamad Rafeek J,Meeramaideen M,Suganthi P,Rajasekar P,Jafar Ahamed A
Asian J. Biol. Life Sci.,11(3):731-736 DOI: 10.5530/ajbls.2022.11.97 Published: Thu, 19-Jan-2023 Read More
Research Article
Biosynthesis of Copper Nanoparticles Using Chitosan Extracted from Prawn Shells, Characterization and Antimicrobial Activity
G Poonguzhali,CM Noorjahan,S Keerthana
Asian J. Biol. Life Sci.,11(3):737-744 DOI: 10.5530/ajbls.2022.11.98 Published: Thu, 19-Jan-2023 Read More
Research Article
Effects of Crude Extracts of Areca catechu L. on Locomotory Behaviour in Drosophila melanogaster
Upendra Sharma US,Shanti Iyer
Asian J. Biol. Life Sci.,11(3):745-750 DOI: 10.5530/ajbls.2022.11.99 Published: Thu, 19-Jan-2023 Read More
Research Article
Determination of Enteroparasites in Long-tailed Macaques (Macaca fascicularis) of Barangay Sumile, Butuan City, Philippines
Hera T. Baloria,Eve F. Gamalinda,Jashin J. Rosal,Leonardo A. Estaño
Asian J. Biol. Life Sci.,11(3):751-756 DOI: 10.5530/ajbls.2022.11.100 Published: Thu, 19-Jan-2023 Read More
Research Article
Oil Extract of Momordica charantia Seed (OEMCS) Exhibits Biphasic Effect on Blood Coagulation, Antiplatelet and Antioxidant Properties
Bhagyalakshmi Manjappa,Devaraja Sannaningaiah
Asian J. Biol. Life Sci.,11(3):757-764 DOI: 10.5530/ajbls.2022.11.101 Published: Thu, 19-Jan-2023 Read More
Research Article
Preliminary Larvicidal Potential of Andrographis Echioides against Dengue Vector Aedes aegypti Larvae
Singaravel Sengottuvelu,Sheik Haja Sherief,John Staines Mark,Chinnadurai Kathirvelan,Banupriya Senthamaraikannan
Asian J. Biol. Life Sci.,11(3):765-768 DOI: 10.5530/ajbls.2022.11.102 Published: Thu, 19-Jan-2023 Read More
Research Article
Extremotolerant Gelatinase Enzyme Production by UCM4 Bacterial Strain Isolated from the Rhizospheric Soil of Rhizophora mangle
Paramashree Deepa BK,Siddaraju M. Nanjundaiah
Asian J. Biol. Life Sci.,11(3):769-775 DOI: 10.5530/ajbls.2022.11.103 Published: Thu, 19-Jan-2023 Read More
Research Article
Deciphering the Evolutionary Relationship of SARS-CoV-2: A Graph Theory Approach
Pranjal Kumar Bora,Sanchaita Rajkhowa,Arun Kumar Baruah,Papori Bora
Asian J. Biol. Life Sci.,11(3):776-784 DOI: 10.5530/ajbls.2022.11.104 Published: Thu, 19-Jan-2023 Read More
Research Article
Medicinal Plants Used by the Traditional Healers of Thimmarajapuram Village, Tirunelveli District, Tamil Nadu, India
Muruganandham Priyadharshana,Mariappan Girija,Veerabagu Smitha,Mariajames Arockia Badhsheeba,Vaikundaraman Vadivel
Asian J. Biol. Life Sci.,11(3):785-793 DOI: 10.5530/ajbls.2022.11.105 Published: Thu, 19-Jan-2023 Read More
Research Article
Study of the Effects of Various Polyphenols on Proliferative Processes and the Functional State of Liver Mitochondria of Experimental Toxic Hepatitis
Surayyo Dalimova,Guzal Mukhammadjonova,Gulbakhor Umarova,Sherali Kuziev,Davron Tukhtaev,Muslima Yunusova,Nigora Khamdamova,Sobir Khamraev,Mahmudjon Gafurov,Feruzbek Khasanov,Farkhod Eshboev
Asian J. Biol. Life Sci.,11(3):794-804 DOI: 10.5530/ajbls.2022.11.106 Published: Thu, 19-Jan-2023 Read More
Research Article